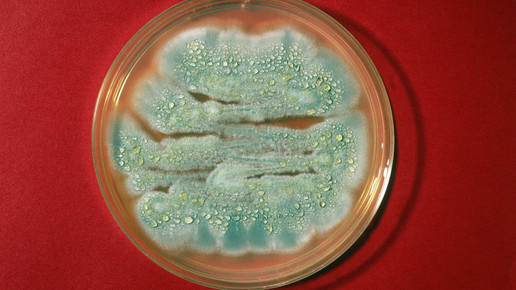

Die erste Tiny-Apotheke Deutschlands
Ihren geplanten Oster-Urlaub hat Apothekerin Jana verschoben – Corona. Eigentlich wollte sie jetzt im August weg, aber nun ist ihre einzige Approbierte ausgefallen und Betriebsferien hat die Kammer abgelehnt. Gut, denkt Jana, wenn ich die Apotheke nicht verlassen darf, muss die Apotheke eben mitkommen.
Die Idee kam ihr, als unlängst eine Kollegin vorübergehend mit ihrer Apotheke in Container umziehen musste, weil drinnen unaufschiebbare Renovierungsarbeiten anstanden. Der Anblick der voll ausgestatteten Offizin vor der Apotheke erinnerte sie das Tinyhouse ihrer Freundin Annika. Die koppelt, wann immer sie eine Luftveränderung braucht, ihre Hütte ans Auto und fährt einfach weg. Warum nicht beides kombinieren, dachte Jana. Das Konzept Tiny-Apotheke war geboren.
40 Quadratmeter muss sie maximal effizient nutzen. Die komplette Freiwahl ist beispielsweise in einem Tablet untergebracht. Der Kunde wählt und wird beliefert. Entweder von ihrem kooperierenden Großhändler (umstritten) oder von ihr selbst. Wenn jetzt auch noch tatsächlich das Botendiensthonorar entfristet wird, kann sich das Konzept sogar lohnen. Fährt sie halt alles aus. Nur enge Altstädte und Sackgassen ohne Wendehammer muss sie meiden.
Aber ansonsten schafft das sich Reduzieren überraschende Freiheiten: Einen Drucker an der Kasse hat Jana einfach eingespart. Sie verstößt zwar jeden Tag hundertfach gegen die Bonflicht, aber bis das Finanzamt das merkt, ist sie längst im nächsten Bundesland. Gilt äquivalent für die DSGVO, als Kundenkarte hat sie sowieso eine App, damit die Patientem sie immer orten können. Es ist ein in gewisser Weise unbeschwertes Leben, wenn man mit der Einschränkung klarkommt, dass man im Labor schlafen muss.
Hier gibt es einen echten Haken: Der Abzug im Mini-Labor funktioniert erst am Tempo 90. Jana muss auf die Autobahn und viel Vertrauen in ihre Pharmazeutisch technischen Spurhalt- und Bremsassistenten (PTS und PTB) haben – ihre besten Mitarbeiter derzeit. Ihre einzigen, denn für mehr Personal ist ohnehin kein Platz in der Minioffizin. Zumindest zu Coronazeiten ist das egal, die Kunden dürfen ohnehin nur einzeln eintreten. Das hat den Vorteil, dass die Offizin gleichzeitig als Beratungszimmer gezählt werden darf.
Aber nach zwei Monaten auf der Straße muss Lena sich ein paar Wahrheiten eingestehen. Erstens: Sie hat immer noch keinen Urlaub gemacht. Zweitens: Ihr Dorf vermisst sie und die flächendeckende Versorgung kann man nur lokal herstellen, was verrückter klingt als es ist. Drittens: Der Pharmazierat hat sich zur Revision angemeldet. Und dann liest Lena auch noch davon, dass der Bundesgerichtshof (BGH) das DocMorris-Prestigeprojekt Hüffenhardt beerdigt hat. Also fährt sie mit ihrem Zuhause nach Hause.
Was die Aufsicht tatsächlich verstärkt kontrolliert sind nicht rollende Apotheke, sondern die Umsetzung der Corona-Vorschriften. Wohl dem, der nicht nur umgebaut, sondern sein Team auch schriftlich eingewiesen hat. Einer der bekanntesten sich Empörer über die Corona-Regeln ist Kochbuchautor Attila Hildmann. Von daher ist es gut, dass er keine Apotheke betreibt sowie aus mannigfachen anderen Gründen. Trotzdem war er über seine Marken in einer Apotheke vertreten, sodass die nichtsahnende Inhaberin einem wahren Shit-Tsunami ausgesetzt war. Wahnhafte Vorstellungen gibt es leider auch auf dieser Seite des HV-Tischs, wie der bayerische Verwaltungsgerichtshof feststellte.
MyLife hat in dieser Woche mit einigen Apotheken-Mythen aufgeräumt Und dabei gleich klargestellt, dass „Apothekenpreise“ früher meinte, dass die Preise sehr genau sind, nicht besonders hoch. Offenbar mit diesem Wissen hat ein Edeka-Markt seine Apotheker-Gasse eröffnet. Die Wettbewerbszentrale schickte die fällige Abmahnung.
Ob die Firma Innocur oder diesen Pfad einschlagen und Apotheken wegen des Vertriebs einer Opiumtinktur als Rezeptur abmahnen wird, bleibt mit Spannung abzuwarten. Denn auch wenn die Apotheken beinahe schon in den Knast gefaxt wurden, wissen alle anderen: Ein Gerichtsbeschluss kettet nicht gleich die ganze Branche an.
Außer er kommt vom EuGH: Auf das Boni-Urteil aus 2016 ist noch immer keine Antwort gefunden. Vielleicht ist das Botendiensthonorar der erste Baustein? FDP-Gesundheitspolitikerin Christine Aschenberg-Dugnus jedenfalls würde das „Boni-Delta“ in der Hand statt des Boni-Verbots auf dem Dach nehmen. Die Apotheker sind laut einer aposcope-Umfrage skeptisch.
Ziemlich entschieden sind die Pharmazeuten offenbar in ihrer politischen Ausrichtung: CDU, CSU oder CDU wird gewählt, am liebsten mit Söder als Kanzler und Merz als neuer Mutti. Na dann, viel Vergnügen…

APOTHEKE ADHOC Debatte